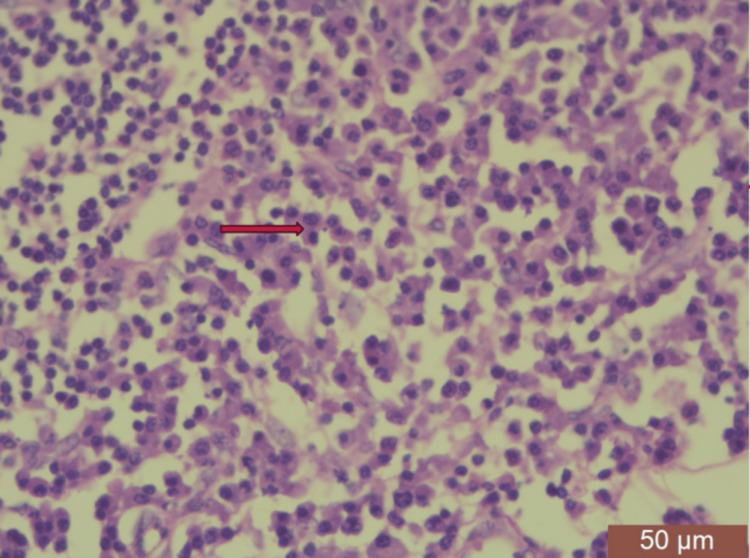
https://cdn.ncbi.nlm.nih.gov/pmc/blobs/5822/10916355/65f122ad8c7e/cureus-0016-00000053612-i07.jpg

Solitary Plasmacytoma of the Breast: A Rare Entity.
作者信息
Shiva Shiva, Gaurav Kushagra, Anand Akshay, Raghuvanshi Shivanjali, Sonkar Abhinav A
机构信息
Surgery, King George's Medical University, Lucknow, IND.
Pathology, King George's Medical University, Lucknow, IND.
出版信息
Cureus. 2024 Feb 5;16(2):e53612. doi: 10.7759/cureus.53612. eCollection 2024 Feb.
Solitary plasmacytoma of the breast is an extremely rare neoplastic entity characterized by the localized proliferation of neoplastic plasma cells within the breast tissue that requires careful consideration due to its clinical and radiological resemblance to more common breast malignancies. While plasmacytomas are typically associated with multiple myeloma (MM), primary involvement of the breast as a solitary lesion is exceptionally rare. In this report, we present a case of solitary plasmacytoma of the breast in a 55-year-old female patient who presented with a palpable breast mass and no signs of systemic multiple myeloma. Our objective is to discuss the clinical presentation, radiological features, and histopathological findings and highlight the importance of comprehensive diagnostic workup and management planning for solitary plasmacytomas of the breast.